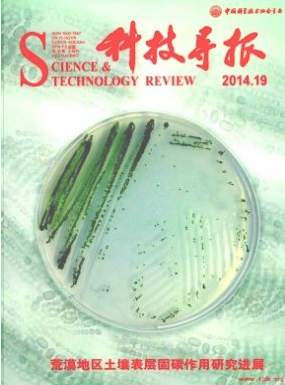
科技導報

《科技導報》期刊簡介:
《科技導報》(旬刊)1980年由楊振寧、李政道等美籍華裔科學家倡議在美國創辦,1984年轉至中國辦刊并正式建社,1986年成為中國科學技術協會學術會刊。錢寧教授、孟昭英院士、朱光亞院士先后任主編,現任主編為中國科學技術協會書記處書記、北京理工大學教授馮長根。作為中國科學技術協會的綜合性學術會刊,《科技導報》立足于科學發展前沿,以面向世界報道中國最優秀的自然科學和工程技術研究成果為己任,將刊物辦成中國的Science和Nature為奮斗目標,積極反映國內外科學技術領域的新理論、新發現、新創造、新方法,廣泛地開展國內外學術交流,力圖展示世界科學技術發展的進程和水平。

辦刊宗旨:
《科技導報》以發表國內外科學技術各學科專業原創性學術論文為主,同時刊登階段性最新科研成果報告,以及國內外重大科技新聞,快速、全方位、高密度、大容量地提供科技信息,力爭辦成一份有影響、有特色、有品位的高層次、高水平、高質量學術期刊。以“刊登原創學術論文,報道前沿科技成果;涵蓋科技各個領域,關注重大科技問題;重視理論研究創新,鼓勵學術觀點爭鳴;促進中外科技交流,探索強國興邦道路”為辦刊宗旨,以“處理來稿周期短,報道成果時效強,探究問題起點高,研討思路視野寬,提出對策著眼遠,爭鳴學術氣氛濃”為辦刊特色,在全國眾多的科技類學術期刊中獨樹一幟。
《科技導報》曾被《農業與生物科學研究中心文摘》、《物理學、電技術、計算機及控制信息數據庫》收錄。
期刊欄目:
卷首寄語、專題論文、研究論文、實驗技術、綜述文章、學術爭鳴、科技評論、科學家之聲、科技動態、信息發布
期刊收錄:
CA 化學文摘(美)CSCD 中國科學引文數據庫來源期刊(含擴展版)Pж(AJ) 文摘雜志(俄)萬方收錄(中)上海圖書館館藏劍橋科學文摘北大核心期刊(中國人文社會科學核心期刊)哥白尼索引(波蘭)國家圖書館館藏文摘雜志知網收錄(中)維普收錄(中)全國優秀科技期刊全國百刊工程期刊
科技導報雜志社征稿要求:
01著作權
敬請本刊作者允諾:稿件中沒有侵犯他人著作權或其他權利的內容;投寄給本刊的稿件(論文、圖表、照片等)自發表之日起,其專有出版權和網絡傳播權即授予本刊,并許可本刊在本刊網站或本刊授權的網站上傳播。
注意,投稿時應提供全部作者的電子信箱地址。
02評審流程
收稿后,稿件將經過編輯部初審、專家外審、主編終審的基本評審流程。文章確定錄用后須繳納版面費200元/版。
特別提示:本刊主要刊登數理化天地生各學科博士研究生以上人員的科研論文,非此范疇請慎重投稿。
03刊載順序
一般以收稿、修改和錄用時間的先后確定刊載順序。具有重大原創性、開拓性、前沿性研究成果,優先刊出。論文出版后,編輯部將贈送???冊。
SCI期刊推薦 >
論文指導 >
職稱論文常見問題 >